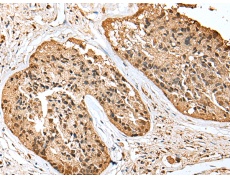
一抗

中文名稱(chēng): 兔抗SCN1A多克隆抗體
英文名稱(chēng): Anti-SCN1A rabbit polyclonal antibody
別 名: FEB3; FHM3; NAC1; SCN1; SMEI; EIEE6; FEB3A; HBSCI; GEFSP2; Nav1.1
相關(guān)類(lèi)別: 一抗
儲(chǔ) 存: 冷凍(-20℃)
宿 主: Rabbit
抗 原: SCN1A
反應(yīng)種屬: Human, Rat
標(biāo) 記 物: Unconjugate
克隆類(lèi)型: rabbit polyclonal
技術(shù)規(guī)格
|
Background: |
The vertebrate sodium channel is a voltage-gated ion channel essential for the generation and propagation of action potentials, mainly in nerve and muscle. Voltage-sensitive sodium channels are heteromeric complexes consisting of a large central pore-forming glycosylated alpha subunit, and two smaller auxiliary beta subunits. This gene encodes the large alpha subunit, and mutations in this gene have been associated with several epilepsy, convulsion and migraine disorders. Alternative splicing results in multiple transcript variants. The RefSeq Project has decided to create four representative RefSeq records. Three of the transcript variants are supported by experimental evidence and the fourth contains alternate 5' untranslated exons, the exact combination of which have not been experimentally confirmed for the full-length transcript. |
|
Applications: |
ELISA, IHC |
|
Name of antibody: |
SCN1A |
|
Immunogen: |
Synthetic peptide of human SCN1A |
|
Full name: |
sodium channel, voltage gated, type I alpha subunit |
|
Synonyms: |
FEB3; FHM3; NAC1; SCN1; SMEI; EIEE6; FEB3A; HBSCI; GEFSP2; Nav1.1 |
|
SwissProt: |
P35498 |
|
ELISA Recommended dilution: |
5000-10000 |
|
IHC positive control: |
Human prostate cancer |
|
IHC Recommend dilution: |
25-100 |

 購(gòu)物車(chē)
購(gòu)物車(chē) 幫助
幫助
 021-54845833/15800441009
021-54845833/15800441009